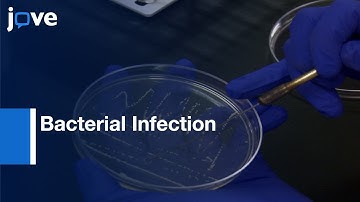
Bacterial Infection and Immune Defense Phenotypes in Fruit Fly | Protocol Preview

⬇ DOWNLOAD NOW
Kalau muncul iklan pop-up, tutup lalu klik tombol kembali
Download lagu Foodborne Bacterial Pathogens Detection from Filth Flies | Protocol Preview secara gratis hanya untuk keperluan promosi. Dukung artis favorit kamu dengan membeli musik original di iTunes atau platform resmi lainnya.
 This is the reason Flies are not wanted to land on food. 🔥👀😎🫵
This is the reason Flies are not wanted to land on food. 🔥👀😎🫵
 Assessing Immunological Responses Against Bacterial Pathogens-Preview
Assessing Immunological Responses Against Bacterial Pathogens-Preview
Bacterial Infection and Immune Defense Phenotypes in Fruit Fly | Protocol Preview
Bacterial Infection and Immune Defense Phenotypes in Fruit Fly | Protocol Preview
 Filthy Flies
Filthy Flies
 Basics of Foodborne Pathogens - Webinar
Basics of Foodborne Pathogens - Webinar
 Can Fruit Flies Transfer Pathogens?
Can Fruit Flies Transfer Pathogens?
 THE BIG SIX- E-COLI
THE BIG SIX- E-COLI
 Discover the Future of Food Safety: PCR-Based Foodborne Pathogen Detection!
Discover the Future of Food Safety: PCR-Based Foodborne Pathogen Detection!